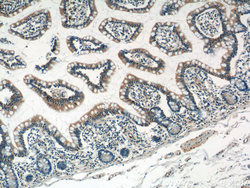

Antibody data
- Antibody Data
- Antigen structure
- References [3]
- Comments [0]
- Validations
- Western blot [1]
- Immunohistochemistry [1]
Submit
Validation data
Reference
Comment
Report error
- Product number
- 18057-1-AP - Provider product page

- Provider
- Proteintech Group
- Proper citation
- Proteintech Cat#18057-1-AP, RRID:AB_2292842
- Product name
- DEFA1 antibody
- Antibody type
- Polyclonal
- Description
- DEFA1 antibody (Cat. #18057-1-AP) is a rabbit polyclonal antibody that shows reactivity with human and has been validated for the following applications: IF, IHC, WB, ELISA.
- Reactivity
- Human
- Host
- Rabbit
- Conjugate
- Unconjugated
- Isotype
- IgG
- Vial size
- 20ul, 150ul
Submitted references Histone deacetylase 6-mediated downregulation of TMEM100 expedites the development and progression of non-small cell lung cancer.
Identification of differentially expressed proteins associated with recurrence in ovarian endometriotic cysts.
DEFA1B inhibits ZIKV replication and retards cell cycle progression through interaction with ORC1.
Wang Y, Ha M, Li M, Zhang L, Chen Y
Human cell 2022 Jan;35(1):271-285
Human cell 2022 Jan;35(1):271-285
Identification of differentially expressed proteins associated with recurrence in ovarian endometriotic cysts.
Zhu G, Kong J, Fu X, Liu F, Huang H, Hong L, Wang K
Systems biology in reproductive medicine 2020 Feb;66(1):59-69
Systems biology in reproductive medicine 2020 Feb;66(1):59-69
DEFA1B inhibits ZIKV replication and retards cell cycle progression through interaction with ORC1.
Li S, Zhu A, Ren K, Li S, Chen L
Life sciences 2020 Dec 15;263:118564
Life sciences 2020 Dec 15;263:118564
No comments: Submit comment
Supportive validation
- Submitted by
- Proteintech Group (provider)
- Main image

- Experimental details
- HepG2 cells were subjected to SDS PAGE followed by western blot with 18057-1-AP( DEFA1 Antibody) at dilution of 1:300
- Sample type
- cell line
Supportive validation
- Submitted by
- Proteintech Group (provider)
- Main image
- Experimental details
- The DEFA1 antibody from Proteintech is a rabbit polyclonal antibody to a recombinant protein of human DEFA1. This antibody recognizes human antigen. The DEFA1 antibody has been validated for the following applications: ELISA, WB, IHC analysis.